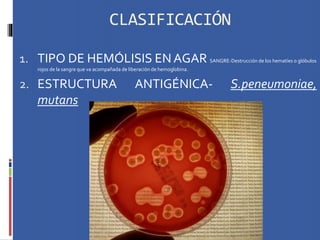
CLASIFICACIÓN
1. TIPO DE HEMÓLISIS EN AGAR SANGRE-Destrucción de los hematíes o glóbulos
rojos de la sangre que va acompañada de liberación de hemoglobina.
2. ESTRUCTURA ANTIGÉNICA- S.peneumoniae,
mutans

Este documento proporciona información general sobre los estreptococos. Explica que son cocos Gram positivos que crecen en cadenas o pares, son anaerobios facultativos y producen ácidos que descienden el pH. Se clasifican según su tipo de hemólisis y estructura antigénica. Incluye detalles sobre estreptococos viridans que colonizan la cavidad oral y son responsables de la formación de placas y caries dentales, y sobre los estreptococos del grupo mutans que son particularmente acidogénicos y adhes